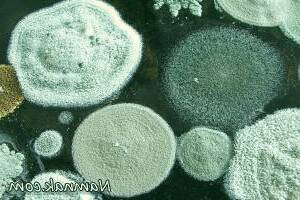

افراد مبتلا به آلرژی های تنفسی ملزم هستند که از هرگونه تماس با عوامل آلرژی زا اجتناب ورزند. این عوامل شامل قارچ ها، اسپورهای کپک و گرده های گیاهان می باشند. این امر بدین دلیل است که در صورت قرارگیری در معرض این عوامل، امکان تشدید علائم آلرژیک و بروز واکنش های شدید تنفسی وجود خواهد داشت. بنابراین، افراد مبتلا به آلرژی های تنفسی باید همواره مراقبت های لازم را به عمل آورده و از هرگونه تماس با این عوامل اجتناب نمایند.
رطوبت یکی از عوامل اصلی بروز کپک و قارچ بین موجودات زنده در دنیا است. برخی از انواع کپک ها به شدت برای سلامت انسان ها مضر هستند و می توانند باعث واکنش های آلرژیک شدید شوند. افرادی که مبتلا به آلرژی های تنفسی و یا حتی پوستی هستند باید حتی الامکان از مجاورت با عوامل تحریک کننده آلرژی از جمله قارچ ها، هاگ کپک ها و گرده های گل ها خودداری کنند. قرار گرفتن در معرض کپک و قارچ ها می تواند در افراد موجب گرفتگی بینی، سوزش گلو، سرفه یا خس خس سینه، سوزش چشم، تاری دید، گلو درد، سرفه مزمن، راش پوستی، واکنش شدید سیستم ایمنی بدن افراد مبتلا به آلرژی، تشدید علائم آسم در افراد مبتلا به آسم و بروز بیماری مزمن ریوی در برخی افراد از جمله بیماری انسدادی ریه شود. کارشناسان برای جلوگیری از ایجاد مشکلات سلامتی در ارتباط با قارچ ها و کپک ها به افراد توصیه های زیر را می کنند.
لولای درب و پنجره ها را به طور دائم تمیز کنید تا مانع از ورود گرد وخاک و آلودگی به محیط خانه شوید، درون خانه به طور منظم گردگیری ونظافت با وسایل دارای فیلتر انجام دهید تا از رشد میکروب وقارچ جلوگیری کنید. فضای درون حمام و سرویس بهداشتی را به طور منظم نظافت کنید زیرا این قسمت از خانه به دلیل فضای مرطوب خود بسیار مستعد رشد قارچ و کپک ها هستند. پس از ورود به منزل بویژه در فصل بهار حتماً استحمام کرده کلیه البسه خود را عوض کنید، در صورت وجود علائم فوق و حساسیت به پزشک متخصص مراجعه کرده تا با تشخیص دقیق نوع آلرژی بتواند راهنمایی ها و روش های درمانی لازم را به شما معرفی کند.